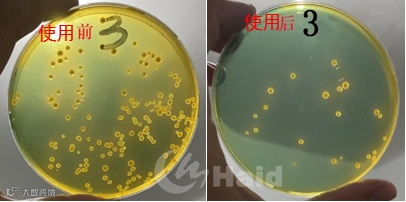

文 | 图 浙江海大 曹毅 动保事业部 李朋非
一、愁!加不上料
送走梅雨期,又迎来了高温期
2020年的梅雨期,比往年都走的晚了一些,别看就多了20来天,却让养殖户朋友们苦不堪言。
梅雨期加不上料,高温期不敢加料;梅雨期担心病毒性疾病,高温期又担心细菌性疾病;梅雨期担心水难肥,高温期又担心水太浓。不仅闹的养殖户夜夜不能寐,也让白虾“遭老罪”了。
在养殖大环境这般艰难的时候,却有这么一批养殖户,当别的养殖户都在控料的时候,他们却在一边笑一边加料,最诧异的是他们养的虾子个个“五大三粗”!
二、他们加料猛,虾子还都“五大三粗”
加不上料的愁,他们也遇到过
01
绍兴 赵老板

塘口拜访
“前段时间东1塘口正常吃料60-70斤/天,一个小时保准吃完,这两天也不知道咋回事,吃料慢了。现在一天投喂45斤,得吃两个小时左右,真是头疼!
哎~不行的话卖了得了!对了,还有这个东5号塘,你再帮我看看色素咋样,上次出了问题也没管它。”
2020年7月26号下午,我们拜访了赵老板,询问得知没有偷死、游虾的情况下,工程师现场用三角兜进行刮底以及虾体肠道镜检。
解决方案
了解到前期虾塘使用钙镁佳、虾多宝等产品,同时针对不良天气不适合消毒,因此建议健多宝:饲料=1:1进行拌喂。
处理结果
7月29号回访,赵老板表示东1塘吃料情况明显好转,分别对1号和5号塘进行肠道镜检。

使用前后,塘口对比
1号塘
5号塘
使用前:5号塘扩散明显,呈雪花状。
使用后:5号塘相较于处理前肠道色素和颜色都开始好转。
原因分析
前期正处于控料期间以及7月24-25号气温骤降(最高温27℃,最低温21℃)导致原本营养跟不上的基础上产生应激反应,最终导致对虾吃料慢,食欲不振,肠炎的发生。
赵老板表示:真是帮了大忙了,趁着这两天天气好,不用担心吃料的情况了,这个健多宝挺好的。
02
上海奉贤 朱老板

塘口拜访
“这怎么可能?看着这水,虾肯定好好的,不会出问题的。”
2020年7月19号拜访朱老板,应邀查看料台,发现对虾空肠胃现象(占比10%),当时投喂量为60斤/餐(控料),清料台时间为3-4小时,随后对肠道进行镜检以及对虾肝脏弧菌检测。
结果显示:肠道色素呈梭形,并开始扩散;弧菌检测显示弧菌较多。整体分析朱老板虾塘目前处于肠炎早期。工程师表示肠炎早期确实是对虾的摄食不会有太大的变化,但是如果你最近加料的话,虾子容易出问题,最后吃不完的饲料还会影响水质。
处理方案
处理结果
7月29日再次进行拜访,朱老板大老远就来迎我们,表示现在虾子一天比一天好,一天都吃160斤了,就这吃料速度感觉还能再加点料。
到塘口对虾体肠道再次进行镜检以及肝脏弧菌检测:肠道色素明显改善,弧菌数量明显减少。

朱老板说:“这个健多宝确实挺好的,幸亏你们及时提醒了我,太感谢了。”当天朱老板就拉着不让服务工程师们走了,硬是让老板娘杀只鸭表示感谢。
03
上海金山 朱老板

塘口拜访
“2号塘和7号塘近一个月都不怎么加料了,拌了点发酵料也不行,差不多两个小时才吃完。”
7月25号进行拜访,工程师查看料台发现空肠胃虾,占比30%左右,肠道镜检结果较差,颜色相对较好,但肠道色素均开始扩散,属于肠道炎症早期。
王老板认为吃不上料可能是弧菌因起的,想杀一杀水里的有害物质,目前在使用靓底进行消毒,不过感觉效果不明显。
工程师解释道:引起肠炎慢料的原因有很多,当然也包括弧菌。消毒减少水质中的有害菌,可以从源头进行切断。但是目前虾体里已经存在弧菌的话,只是清水治弧菌是事倍功半的,需要让虾子吃到肠胃里才能充分的抑制体内的弧菌。
处理方案
处理结果
7月30号再次拜访,王老板高兴的拿出投喂记录本让我们看:“你看,现在2号和7号塘吃料明显上去了,吃料速度好像也快了一点,后期还准备加料。还有其他几个塘我也准备用用这个健多宝,要是料都加上去,今年我就发财了!”
工程师随后对2、号塘虾肠道进行镜检:肠道颜色较黑,形状也开始趋于圆形,整体分布较为均匀,与使用前相比,明显好转。


除此之外,包括浙江萧山的张老板、沈老板同样针对目前对虾肠炎慢料的情况使用健多宝,都出现不同程度的好转。因此在对虾养殖界出现了这样的顺口溜:
高温倒藻水难搞,对虾肠炎少不了,
慢料偷死真的恼,促投首选健多宝。
从这几个案例里面,我们不难看出这三个客户都出现一些共性问题:那就是不同程度的出现空肠胃现象、加不上料,肝脏弧菌检测比较严重,同时肠道色素均出现不同程度的扩散,也就是肠道出现炎症了。
那么针对肠道炎症怎么做呢?
哪出问题就治哪!
既然是对虾肠道出了问题,
那就得从“吃”下功夫。
这几个客户的处理措施主要包括
1、水体进行消毒杀菌(靓底/水卫士/聚维酮碘),保证对虾生长环境的健康,减少对虾摄食有害物质量,称之为外消;
2、让对虾摄食含有药物的饲料,或者有药效的饲料(虾多宝+健多宝),称之为内服。双管齐下才能事半功倍,药到病除。
三、什么是健多宝?

健多宝,是一款虾用配合饲料,因其成分包括血球蛋白粉、鱼粉,因此必要时可作为饲料进行纯投喂,营养水平足够,不会影响对虾的正常生长;除此之外,健多宝可以促进肠道有益菌乳酸菌、多歧杆菌的增殖,抑制有害菌的生长,从而维持肠道微生物菌群的平衡。产品中包含多种中草药成分,有效保护虾子机体健康。
整体而言,健多宝的主要作用机理包括:(1)速消炎;(2)准修复;(3)强免疫。
四、健多宝如何使用?
1、养成预防大于治疗的意识,所有的产品都是在预防时期起到最大效果,一旦病入膏肓,基本无药可救;
2、针对健多宝的使用,一般预防时期(空肠胃以及大便长度情况较轻,料台占比0-20%)时一般为1:2-1:3进行拌喂;中期(空肠胃以及大便长度情况较重,料台占比20-40%)时,一般为1:1或者纯投喂。健多宝使用一般4天一个疗程,一天一顿下午投喂。
3、通过外消内服(水卫士/靓底+虾多宝+健多宝)才能从源头遏制有害菌的生长,恢复肠道健康,恢复正常投喂量。
总 结
养殖界的一健三连:“一健”就是健多宝,连着“肠炎”、“慢料”、“清弧菌”三大难点问题。
有这样的制胜法宝,加料加到你惊讶!
海大农牧
接地气的水产一线技术
长摁二维码,即刻关注

